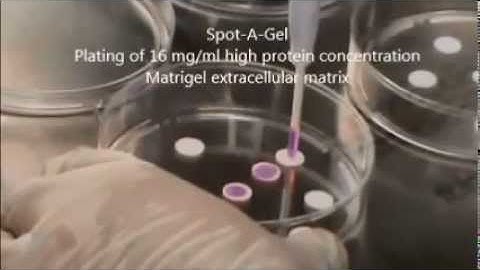
Spot an extracellular matrix barrier - SeedEZ Video Tutorial

⬇ DOWNLOAD NOW
Kalau muncul iklan pop-up, tutup lalu klik tombol kembali
Download lagu Modelling cell migration strategies in the extracellular matrix secara gratis hanya untuk keperluan promosi. Dukung artis favorit kamu dengan membeli musik original di iTunes atau platform resmi lainnya.
 Extracellular Matrix Animation: Quantifying Tissue Remodeling through the Nordic ProteinFingerPrint™
Extracellular Matrix Animation: Quantifying Tissue Remodeling through the Nordic ProteinFingerPrint™
 Cell–Extracellular Matrix Mechanobiology
Cell–Extracellular Matrix Mechanobiology
 lifETIME project: Extracellular Matrix Controls Cell Behaviour by Modulating Attractant Diffusion
lifETIME project: Extracellular Matrix Controls Cell Behaviour by Modulating Attractant Diffusion
 visualisation of migrating MV3 melanoma cells through a collagen matrix
visualisation of migrating MV3 melanoma cells through a collagen matrix
 Mesenchymal mode of cell migration
Mesenchymal mode of cell migration
 Cell Migration | Cell Bio | Video Textbooks - Preview
Cell Migration | Cell Bio | Video Textbooks - Preview
Spot an extracellular matrix barrier - SeedEZ Video Tutorial
Spot an extracellular matrix barrier - SeedEZ Video Tutorial
 Computational model of cellular network formation in mesenchymal cells
Computational model of cellular network formation in mesenchymal cells